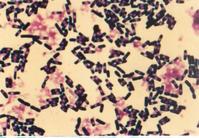

阿狄森氏病
原发性肾上腺皮质功能减退症又称阿狄森氏病,是由肾上腺皮质本身的病变所致,1855年首先由英国医生Addison氏所描述。其主要病因是结核、癌瘤及特发性萎缩,在我国及日本主要是结核造成的肾上腺组织破坏,约占全部病例的68%。
概述[编辑 | 编辑源代码]
慢性肾上腺皮质机能减退症(又称“阿狄森氏病”)是由结核、自身免疫等原因破坏双侧肾上腺的绝大部分,而致肾上腺皮质激素分泌不足所引起的疾病。色素沉着为其临床特征,其次为乏力、体重减轻、胃肠道紊乱,血压降低、低血糖表现、严重视力模糊、神经症状表情淡漠等。严重的可引起休克、昏迷。慢性肾上腺皮质机能减退为少见的内分泌疾病,男性居多。
中医学对本病未见系统论述,但结合本病临床表现,与中医学中的“黑疸”、“黑瘅”、“女劳疸”、“虚劳”等有类似之处。在《黄帝内经》中首先论述了黑色归于肾的理论,并在《素
问?痿论》中有“肾热者,色黑而齿槁”之病症描述;在《金匮要略》中已定名为“黑疸”,其症为“额上黑”,并指出“此为女劳得之”。嗣后,在《续名医类案》中有“满面皆黑色”的病案介绍。清代张仲华《爱庐医案》中之黑疸病案,其症见“肌肤舌质尽黑,手指肤间俱黯”,不仅有“额上黑”,而且有舌黑、指黑,更酷似阿狄森氏病。对本病病因病机的认识,也从外感六淫,邪气久羁而向元阳不足、命门火衰转化。从肾论治成为治疗本病之大法。
运用中医药治疗阿狄森氏病,首次报道见于1956年,同年以甘草流浸膏或甘草粉治疗阿狄森氏病的就有4篇。此后,陆续有按中医辨证论治原则施治或针灸治疗的临床报告出现,包括集中观察达35例的临床资料,还提出了气血两虚,肝肾阴虚,脾肾阳虚的三型分证的辨证方案,也有将本病作为疑难病案进行讨论分析,强调本病与肾及命门的关系,且认为病属虚劳,表明中医理论对本病的认识正在进一步深化。
病因[编辑 | 编辑源代码]
从中医而论,主要从其临床表现审证求因。其病因可归纳为先天不足,五脏柔弱;外感六淫,迁延失治;烦劳过度,饮食不节;大病之后,失于调理等。
本病病机,诸医家较统一的认识是,应归之肾虚。无论外感痨疾,或内伤烦劳,大病体虚,其损均在肾,影响元阴元阳。如为肾阳虚衰,则不能温煦血脉,以致经行不畅,瘀浊外露;如为肾精失藏,精衰则阳不振,致使阴寒内盛,寒则凝滞,血气失运脉络瘀阻。肾阴肾阳虚衰,则导致其他脏腑和全
身虚弱,冲任失调,而现诸证。
慢性肾上腺皮质机能减退诊断具有特征性的为皮肤、粘膜色素沉着。实验室检查水试验如排尿量显著降低,而在服用皮质素后可明显得到纠正,具有诊断价值。ACTH兴奋试验可显示肾上腺皮质缺乏储备能力等。
现代医学对慢性肾上腺皮质机能减退应用一般治疗、激素替代治疗、病因治疗及并发症治疗等。
病理[编辑 | 编辑源代码]
是由肾上腺皮质组织破坏(至少破坏95%以上)所引起。病因多为自身免疫和肾上腺皮质结核,其他为感染、炎症、破坏性肿瘤和肾上腺的淀粉样变。主要症状为缺乏糖皮质激素和盐皮质激素的表现,如:肌无力、虚弱、极易疲劳、心动微弱、经常恶心、呕吐、低血糖、体重减轻、血Na+降低、血K+升高、失水、低血容量、低血压、肾功能障碍及抵抗力降低等。此外,还有特征性的皮肤、粘膜色素沉
着。色素沉着以面部、关节屈伸面和皮肤皱折而受磨擦处,以及乳头、乳晕、生殖器、肩腋部、下腹中线、指(趾)甲根部等处最明显。色素深浅不一,深者如焦煤、浅者呈棕黄色或古铜色。其机制是由于失去糖皮质激素对腺垂体的反馈抑制作用,使促肾上腺皮质激素(ACTH)和促黑色素细胞刺激素(MSH)的释放增加,而ACTH肽链的前13个氨基酸与MSH的完全相同,也能促进黑色素形成,二者一起引起色素沉着。
辨证分型[编辑 | 编辑源代码]
阿狄森氏病以色素沉着为主要症状,随着其他伴随症状之主次表现不同,在中医辨证中,基于黑色归咎于肾,故虽有所分型,但大都仍涉及肾阴、肾阳。综舍临床报道,大体划分为以下四型:
1.肾阳不足面部黧黑,两手晦暗,精神不振,倦怠无力,少气懒言,畏寒肢冷,腰膝酸软,阳痿不举,下肢浮肿。舌质紫暗,舌苔薄白,脉沉细弱。本型为阿狄森氏病的基本证候,每一病例几乎均见有本证之某些表现,随其他症候表现之显露而归属于其他诸型。
2.脾肾两虚面色苍黑无华,头昏神疲乏力,纳呆脘腹胀满,间或恶心呕吐,大便次频质溏,形体消瘦软弱,四肢色黯欠温,腰腿酸软无力。舌质淡暗,苔薄,脉沉濡细。本型以肠胃型为主要表现,常以食欲不振为早期症状,较重者可伴有腹痛,易误诊为溃疡病等消化系统疾病,后期出现低血压、色素沉着症。
3.肝肾阴虚面色晦暗,午后两颧发赤,目眶黯黑,皮肤干燥色枯,发枯不泽或脱发,
形体明显消瘦,精神萎靡不振,间或烦躁易怒,夜间潮热盗汗,失眠多梦,头晕目花,软弱无力。舌质暗红或绛,舌苔薄少,脉沉细弦涩。本型常系肾上腺结核患者的临床表现,在肾上腺区x线平片上常可发现钙化阴影,可作为本病系结核性的有力佐证。
4.气血两亏头昏神疲,肢软无力,心悸气促,纳差消瘦,肤黯干燥,面黑欠华,发枯稀疏,肢颤汗多,男子阳痿,女子经少。舌淡暗,苔薄白,脉沉细迟。本型大都属低血压型,常常在脾肾阳虚的基础上形成全身气血亏乏,尤以气虚之表现明显,血亏系由营养不良所致,但叉兼有血瘀之表现。
专方治疗[编辑 | 编辑源代码]
现代医学认为慢性肾上腺皮质机能减退病因是肾上腺结核造成皮质机能减退;特发性肾上腺萎缩与自身免疫有关;其他较少见病因有恶性肿瘤、全身霉菌感染、全身性淀粉样变性、先天性肾上腺发育不全。
慢性肾上腺皮质机能减退在中医临床中属于“黑疸”的范畴。根据临床所见,中医辨证为肾阳虚衰,阳不化水,痰浊内阻所致。肾阳虚衰,不能为脾胃蒸化水谷,运其精微,五脏失养,精血内夺,肾精失藏,肾精生骨髓,脑为髓之海,因髓海不足,可引起眩晕;精血相生,精亏则血虚,故心慌、消
瘦等。精又与气相辅相成,精亏则气衰,故见困倦乏力、抵抗力降低等。精衰则阳不振,致使阴寒内盛,寒则凝滞,从而导致血行不畅。肾为先天之本,是一切活动能力的本源。如肾阳不足,不能温养下焦则产生腰酸、肢冷;阳不化水而产生浮肿;阴寒内盛,气血被阻,故见面部黧黑等。
四逆肾气汤[编辑 | 编辑源代码]
组成:附子9克,肉桂3克,生熟地各12克,淮山药12克,山萸肉9克,泽泻12克,茯苓12克,丹皮9克,干姜3克,甘草30克,龙齿30克,磁石30克。
用法:每日剂,水煎服。
疗效:治疗1例,20剂后黑色十退六七。
右归丸加减[编辑 | 编辑源代码]
组成:熟地、淮山药、茯苓、丹参各15克,山茱萸、枸杞、菟丝子、杜仲、当归各12克,鹿角胶、龟版胶、附子各10克,肉桂5克,田七粉3克,甘草3克。
用法:每日剂,水煎服。
疗效:治疗1例,服药5个月诸症减轻,继续服药6个月,诸症全消。
医学原理[编辑 | 编辑源代码]
又称慢性肾上腺皮质功能减退症。是由肾上腺皮质组织破坏(至少破坏95%以上)所引起。病因多为自身免疫和肾上腺皮质结核,其他为感染、炎症、破坏性肿瘤和肾上腺的淀粉样变。主要症状为缺乏糖皮质激素和盐皮质激素的表现,如:肌无力、虚弱、极易疲劳、心动微弱、经常恶心、呕吐、低血糖、体重减轻、血Na+降低、血K+升高、失水、低血容量、低血压、肾功能障碍及抵抗力降低等。此外,还有特征性的皮肤、粘膜色素沉着。色素沉着以面部、关节屈伸面和皮肤皱折而受摩擦处,以及乳头、乳晕、生殖器、肩腋部、下腹中线、指(趾)甲根部等处最明显。色素深浅不一,深者如焦煤、浅者呈棕黄色或古铜色。其机制是由于失去糖皮质激素对腺垂体的反馈抑制作用,使促肾上腺皮质
激素(ACTH)和促黑色素细胞刺激素(MSH)的释放增加,而ACTH肽链的前13个氨基酸与MSH的完全相同,也能促进黑色素形成,二者一起引起色素沉着。
阿狄森氏病Addison又称原发性慢性肾上腺皮质机能减退症,是由于双侧肾上腺皮质萎缩、结核等严重感染或肿瘤等引起的严重破坏,多数是由于结核破坏了肾上腺皮质或双侧肾上腺皮质大部或全部切除所致,引起的肾上腺皮质激素分泌不足所致的疾病,也可继发于下丘脑分泌CRH及垂体分泌ACTH不足所致,但由肾上腺本身引起者多见。此外,还有自身免疫病、严重的精神创伤也可使肾上腺皮质毁坏或萎缩;其余为淀粉样变、肿瘤、梅毒、真菌、血栓等也能破坏肾上腺皮质而影响其功能。
本病常为隐袭性,且以原因未明的胃肠道症状,如食欲减退、腹痛、腹泻为首发症状。正常的胃肠蠕动大概在一定程度上与肾上腺皮质功能有关,但二者的关系仍未明了。除胃肠道症状外,还可呈衰弱无力、体重减轻、色素沉着及血压下降等。
患者以中年及青年为多,年龄大多在20~50岁间,男女患病率几乎相等,原因不明者以女性为多。
本病在严格使用内分泌治疗、抗痨等治疗后,病人寿命大大延长,劳动力亦显著恢复,并可接近正常人。随访观察继续治疗7年以上者,部分病人能正常妊娠及生育,但在分娩期应注意防治肾上腺危象发作。小儿产前产后生长发育完全正常。治疗过程中,病人抵抗力较低,易患呼吸道感染、胃肠功能紊乱,甚而导致肾上腺危象发作,应予注意。
阿狄森氏病的皮肤表现为皮肤、粘膜出现棕黑色色素沉着,以暴露、压迫、摩擦部位最明显,如前额、眼周、四肢屈侧、肩、腋、腰、臀皱襞及掌跖皮纹等处。粘膜如口唇、颊粘膜、牙龈、乳头、乳晕、外生殖器等部位也会出现棕色色素斑。本病除皮肤表现外,还有疲倦、精神萎糜、食欲不振、头晕、心悸、血压降低、恶心、腹痛等症状,记忆力减退,思想不能集中,抑郁,烦躁等。本病常伴有其他内分泌障碍如低血糖,甲状腺机能减退,性机能减退等。
实验室检查显示,血钠降低,血钾升高,血钠血钾比数小于30。血清氯化物降低,血糖降低。X线摄片,肾上腺可见钙化点。
除治疗外,在饮食中应多摄入瘦肉、牛奶、蛋类和新鲜蔬菜等,而且多食用钠盐。
临床表现[编辑 | 编辑源代码]
临床表现为皮质醇缺乏所引起的症状:
全身乏力,虚弱消瘦,皮肤,粘膜色素沉着,皮肤外露部位、关节皱褶处明显色素沉着,同时口腔、唇、舌、颊粘膜均有色素沉着,女性阴毛腋毛减少,男性性功能减退。
病情严重者可导致肾上腺危象,常发生于感染,创伤,手术,分娩,过劳,大量出汗或突然中断治疗等应激情况下。表现为恶心,呕吐,腹泻,严重脱水,血压降低,心律快,脉细弱,常有高热,低血糖症,低钠血症等,可危及生命。
阿狄森氏病的诊断主要依靠血尿皮质醇、血ACTH水平测定。
诊断明确的患者需要肾上腺皮质激素(可的松类)终生替代治疗,遇到感染等应激状况还需要加量。
阿狄森氏病如何防治?[编辑 | 编辑源代码]
为了预防本病发生,必须强调及早治疗各种结核病,尤其是肾结核、副睾结核、肠及腹腔盆腔结核等,对于长期应用糖皮质激素治疗者,应尽量避免对垂体肾上腺的抑制。肾上腺手术切除时也应注意避免本症发生。
本病治疗原则为:①纠正本病中代谢紊乱;②内分泌替代补充治疗;③ 病因治疗;④避免应激,预防危象。 由于本病属慢性过程,必须使病人了解防治本病的基本知识,自觉地尽量避免过度疲劳、精神刺激、受冷、暴热、感染、受伤等应激因素,也须避免呕吐、腹泻或大汗所引起的失钠失水等情况。饮食须富含糖类、蛋白质及维生素,多钠盐少钾盐。如食物中氯化钠量不足,可进服食盐水溶液,每日入量在 10~15g左右,视各人需要而定,以维持电解质平衡。用内分泌治疗者每日仍需3~10g。 本病的最基本疗法除病因治疗外,需长期皮质激素的替代补充。目前常用皮质醇类激素(如可的松、氢化可的松、强的松和强的松龙)和醛固酮类激素(一般采用人工合成的11-去氧皮质酮的各种制剂)治疗。各种激素的剂量系一般病人所需,剂量但应用时必须个别化。